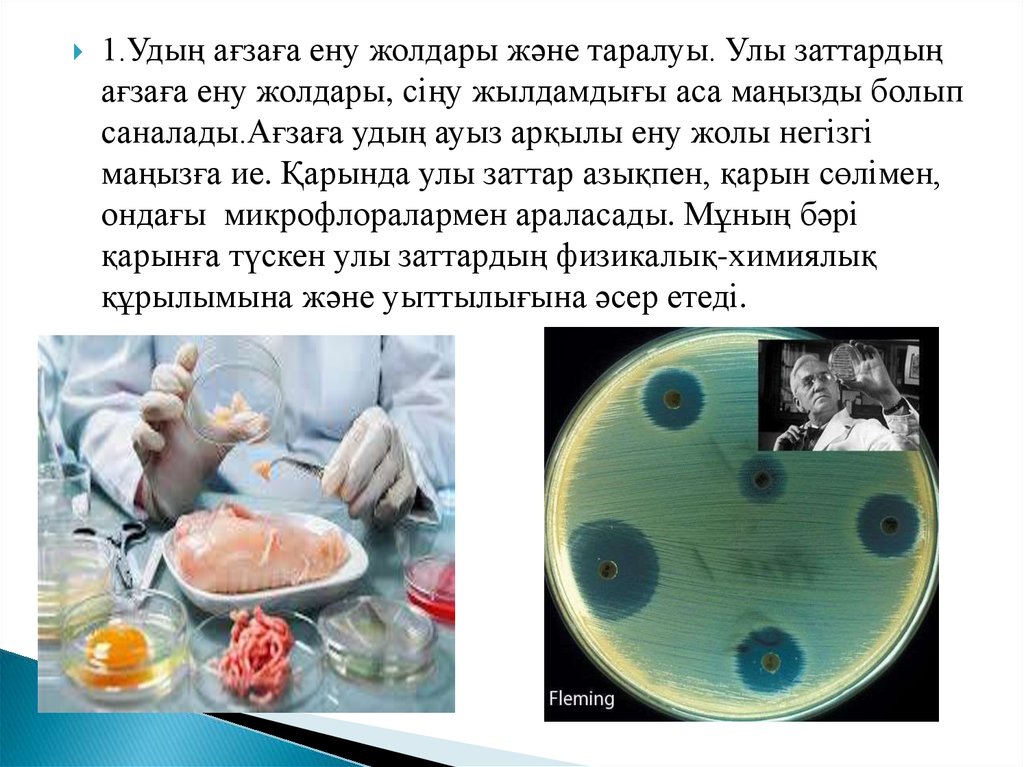

Similar presentations:
Улану деп
1. Жоспар
I. КіріспеII. Негізгі бөлім
1.Удың ағзаға ену жолдары және таралуы
2.Улану кезінде көрсетілетін алғашқы
ветеринариялық көмек
3. Уланудың алдын алу шаралары
III. Қорытынды
IV. Пайдаланған әдебиеттер
2.
Улану деп – жануар ағзасына улызаттар енгенде болатын патологиялық
өзгерістерді айтамыз. Улану уақыты
екіге бөлінеді.
Улану уақыты
Жіті
улану
Созылмалы
улану
3.
Жіті улану – құстарда немесе жануарлардаклиникалық белгілердің кенеттен байқалуымен
және ауыр жағдайда өтумен сипатталады, ол
көбінесе кенеттен болатын өліммен аяқталады.
Жіті улану кезінде ағзаға түскен удың уыттылығы
мен ағзаның жағдайының шешуші маңызы бар.
4.
Созылмалы улану- көбінесе клиникалықбелгілердің жасырын өтуімен және жануарлардың
жалпы жағдайының аз ғана өзгеруімен
сипатталады.Ағзаға ұзақ уақыт ішінде, улы
заттардың аз мөлшерінің енуі,созылмалы
уланудың негізгі себебі болып табылады.
5.
Созылмалы улану, жануарлардың өлуіне әкепсоқтырмайды,бірақ олардың өнімділігін айтарлықтай
төмендетеді.Бұдан бөлек, мұндай жануарларды союға
мәжбүр болған жағдайда, олардың етінде у қалдығының
аздаған мөлшерінің кездесуі мүмкін екенін ескере отырып,
олардан алынған етке сақтықпен қараған жөн.Бұл
әсіресе,паренхиматозды мүшелерге және бірінші кезекте
бауырға тән.
6.
1.Удың ағзаға ену жолдары және таралуы. Улы заттардыңағзаға ену жолдары, сіңу жылдамдығы аса маңызды болып
саналады.Ағзаға удың ауыз арқылы ену жолы негізгі
маңызға ие. Қарында улы заттар азықпен, қарын сөлімен,
ондағы микрофлоралармен араласады. Мұның бәрі
қарынға түскен улы заттардың физикалық-химиялық
құрылымына және уыттылығына әсер етеді.
7.
Улы заттар жалпы жәнежергілікті әсер етеді
8.
Улы заттардың қанға сіңгеннен кейінгі әсеріағзаның қан тамырлар жүйесімен тығыз
байланыста болады. Қандағы өзгерістер қозу және
тежелу түрінде білінуі мүмкін.Қан улы заттарды
бүкіл ағзаға тасымалдайды. Ағзаға түскен улы зат
ұлпалармен өзара әрекеттесу барысында көптеген
өзгерістерге ұшырайды.
9.
Улану кезінде көрсетілетін алғашқы ветеринариялық көмек.Уланубасқа жұқпалы аурулардан айтарлықтай белгілермен ерекшеленетін
категорияға жататын ауру. Жіті улану күтпеген жерден пайда болады.
Сондықтан да, улануды емдеуде шешуші маңызы бар алғашқы көмек,
уланған жануарға дер кезінде көрсетілуі керек. Уланған малға
алғашқы көмекті дәрігер келгенге дейін, мал шаруашылық
мекемелерінің жұмысшылары көрсетуі тиіс.
Ол үшін жануар ағзасына удың ары қарай түсуін тоқтату, ағзаға еніп
кеткен удың әсерін төмендету, уланған жануар өмірін сақтайтын
аралар қолдану.
10.
11. Пайдаланған әдебиеттер
1.Қожанова К.Н., Тойкина Г.Н. “ Малдың азықтануланулары”,Оқу құралы.Семей 2010ж
2.Қорабаев Е.М.,Заманбеков Н.А., Өтенов Ә.М.,
Айтжанов Б.Д.,Көбдікова Н.К., Байнязов В.В
“Токсикология” Дәуір -2011,Алматы.
3. Ильясов Б.К. “ Алғашқы ветеринарлық
жәрдем”,Алматы, 2001ж
4. Муралинов К.К. “Оперативтік хирургия” Алматы
2006ж

medicine
medicine








